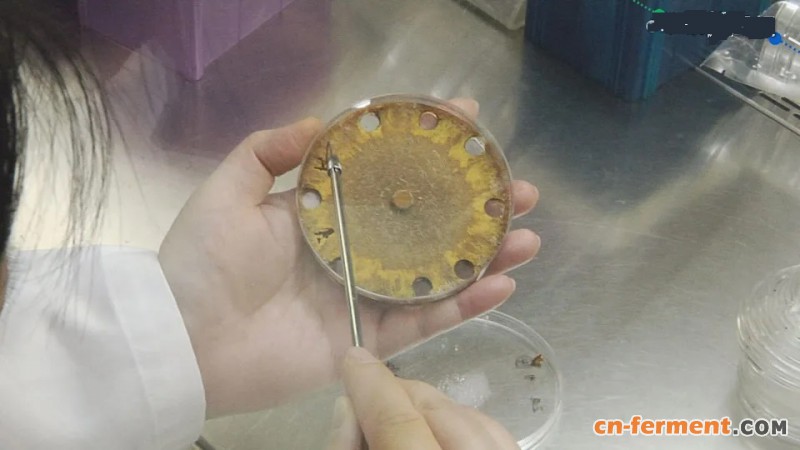
1 (1)

对抗新冠病毒又有最新发现!国立中兴大学研究团队,发现牛樟芝的特有成分「樟芝酸」,能有效预防新冠病毒感染,团队解释,因为冠状病毒需要和血管收缩素转化酶2结合,才能进入宿主细胞,而樟芝酸可以显著抑制血管收缩素转化酶2,进而防止新冠病毒感染人体,虽然目前没进行动物试验及临床试验,但而这项研究已经通过审查,将会在国际期刊植物上刊登发表。
研究员小心翼翼,将培养皿中的牛樟芝菌丝体抽取出来,里面含有19种樟芝酸,研究发现,其中4种樟芝酸,可以有效的抑制新冠病毒感染,中兴大学研发中心主持人王升阳说:「樟芝酸A、B、C跟I这4个樟芝酸,它可以很显著去抑制这个细胞的表达,刚才讲的这个血管收缩素转化酶2,那换句话说它就是很有可能,可以去避免我们接触到病毒之后,病毒来感染你的细胞。」
研究团队解释,冠状病毒需要和血管收缩素转化酶2结合,才能进入宿主细胞,而牛樟芝特有的樟芝酸,可以显著的抑制血管收缩素转化酶2,让它无法和冠状病毒结合,进而阻止感染、生病,这项发现,将在8月20日发表在国际期刊植物,而且不只樟芝酸,研究团队也发现,天竺葵和柠檬精油,也有同样的阻断机制。
中兴大学研发中心主持人王升阳说:「新冠病毒这样的例子来讲,我是建议就是用闻的,那闻的方法可利用家里面的喷雾,这种东西让家里的空气里面,有这样子成分存在直接用鼻子去闻。」研究团队指出,天竺葵精油中的香茅醇,以及,柠檬精油里的柠檬烯,也能抑制血管收缩素转化酶2和冠状病毒结合,达到阻止感染的效果





















































